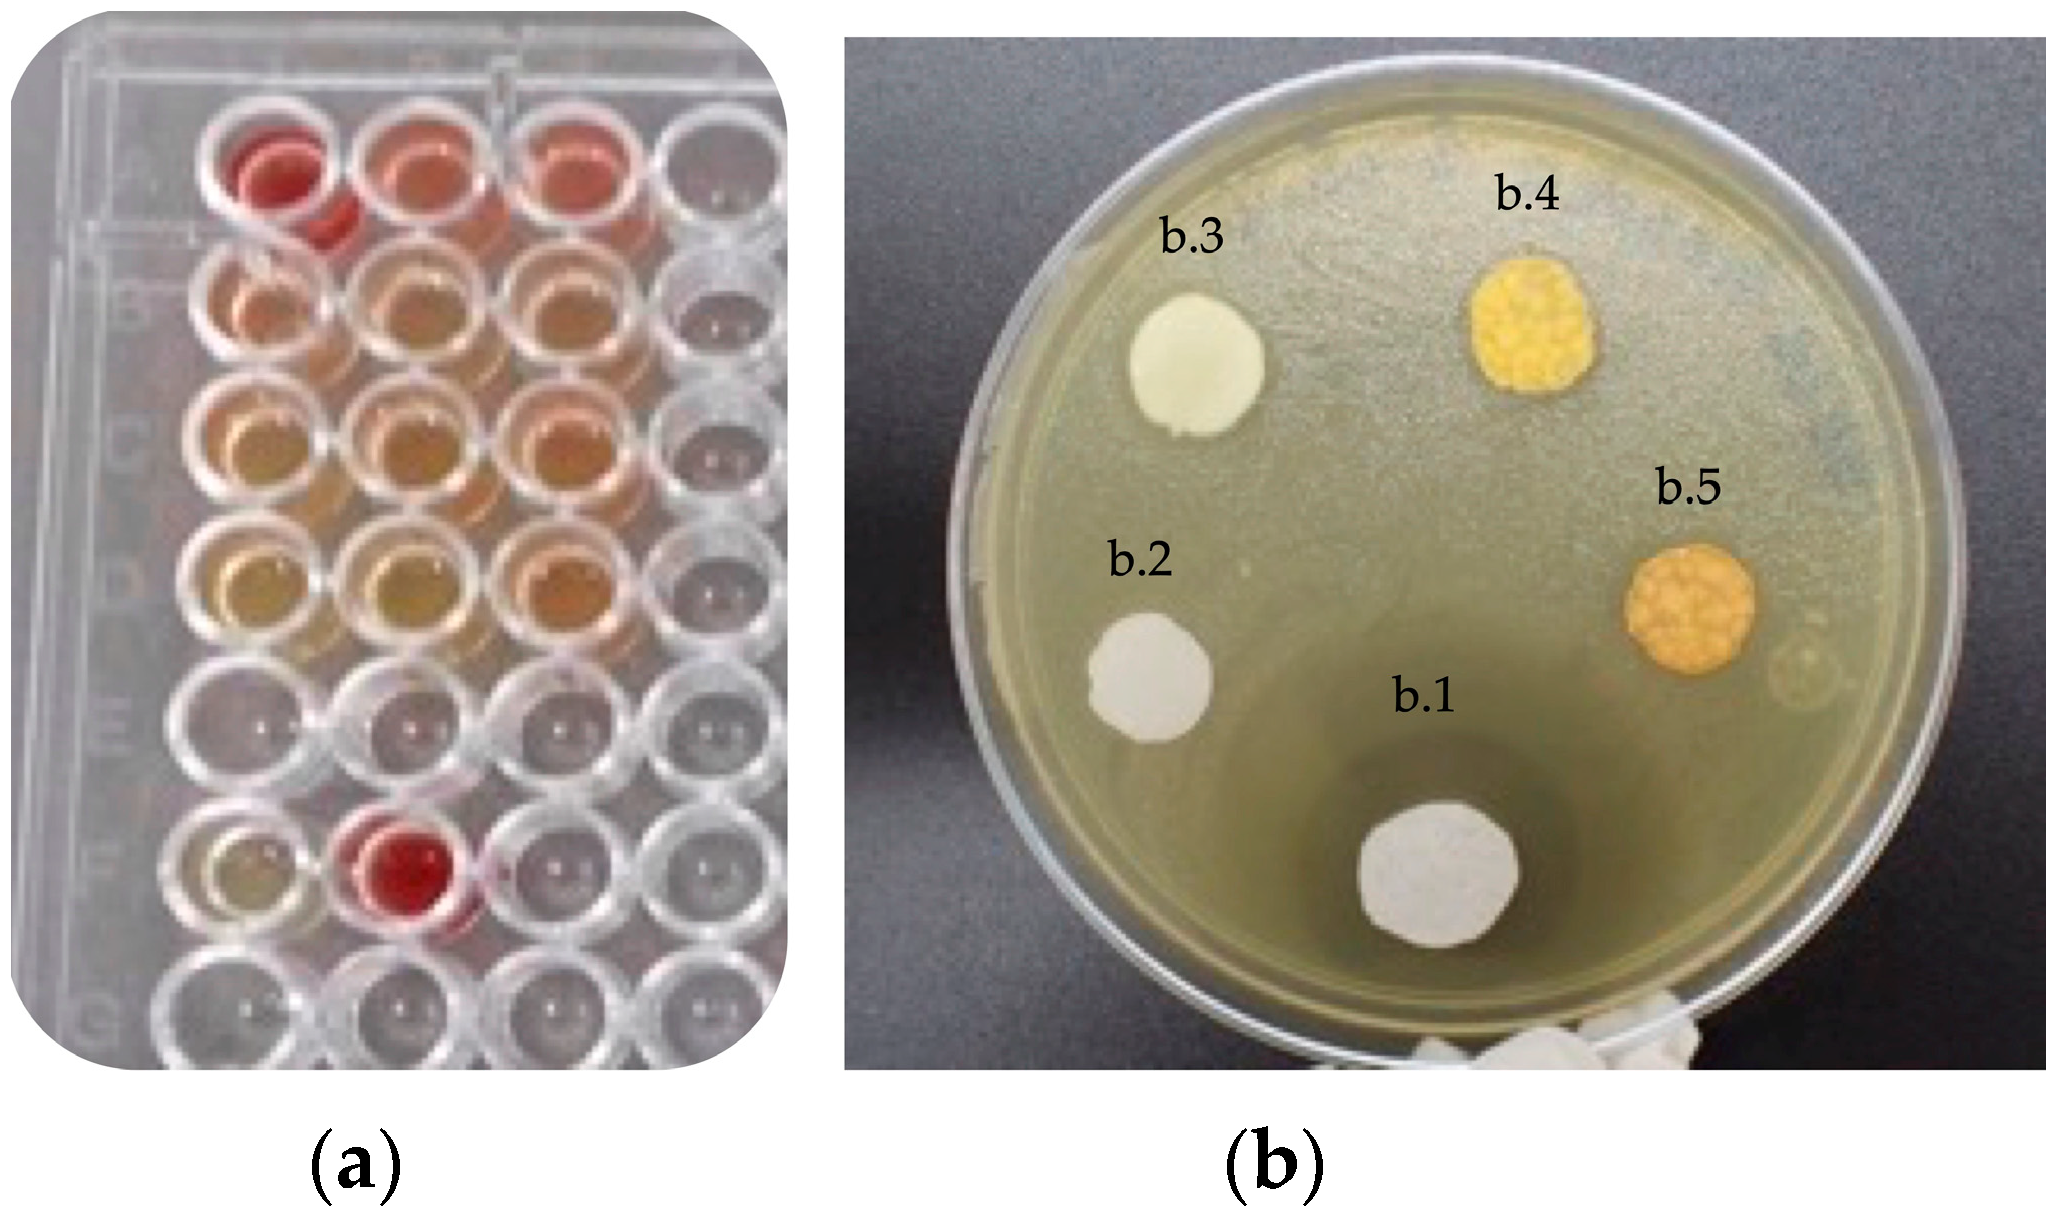
Polymers 15 01676 g004

Mechanical Properties of Poly(Alkenoate) Cement Modified with Propolis as an Antiseptic
Abstract
1. Introduction
2. Materials and Methods
2.1. Materials
2.2. Preparation of PAC and Modified PAC (MPAC)
2.3. Physicochemical Characterization of PAC and MPAC
2.4. Microbiological Test
2.5. Mechanical Characterization
2.5.1. Compressive
2.5.2. Three-Point Bending
2.5.3. Shear Bond Test
2.5.4. Pull-Out Test
2.6. Statistical Analysis
3. Results
3.1. Physicochemical Characterization
3.2. Antibacterial Properties
3.3. Mechanical Properties
3.3.1. Compressive Strength
3.3.2. Bending Strength
3.3.3. Shear Bond Strength
4. Discussion
5. Conclusions
Author Contributions
Funding
Institutional Review Board Statement
Data Availability Statement
Acknowledgments
Conflicts of Interest
References
- Xie, D.; Brantley, W.; Culbertson, B.; Wang, G. Mechanical properties and microstructures of glass-ionomer cements. Dent. Mater. 2000, 16, 129–138. [Google Scholar] [CrossRef] [PubMed]
- Sidhu, S.K.; Nicholson, J.W. A Review of Glass-Ionomer Cements for Clinical Dentistry. J. Funct. Biomater. 2016, 7, 16. [Google Scholar] [CrossRef] [PubMed]
- Hatton, P.V.; Kearns, V.R.; Brook, I.M. Bone-Cement Fixation: Glass-Ionomer Cements. In Biomaterials; Woodhead Publishing: Sawston, UK, 2008; pp. 252–263. [Google Scholar]
- Zandi Karimi, A.; Rezabeigi, E.; Drew, R.A.L. Glass ionomer cements with enhanced mechanical and remineralizing properties containing 45S5 bioglass-ceramic particles. J. Mech. Behav. Biomed. Mater. 2019, 97, 396–405. [Google Scholar] [CrossRef] [PubMed]
- Calvo, A.F.B.; Kicuti, A.; Tedesco, T.K.; Braga, M.M.; Raggio, D.P. Evaluation of the relationship between the cost and properties of glass ionomer cements indicated for atraumatic restorative treatment. Braz. Oral Res. 2016, 30, 3–9. [Google Scholar] [CrossRef]
- Chen, S.; Mestres, G.; Lan, W.; Xia, W.; Engqvist, H. Cytotoxicity of modified glass ionomer cement on odontoblast cells. J. Mater. Sci. Mater. Med. 2016, 27, 116. [Google Scholar] [CrossRef]
- Nicholson, J.; Brookman, P.; Lacy, O.; Wilson, A. Fourier Transform Infrared Spectroscopic Study of the Role of Tartaric Acid in Glass-ionomer Dental Cements. J. Dent. Res. 1988, 67, 1451–1454. [Google Scholar] [CrossRef]
- Nicholson, J.W. Adhesion of glass-ionomer cements to teeth: A review. Int. J. Adhes. Adhes. 2016, 69, 33–38. [Google Scholar] [CrossRef]
- Fierascu, R.C. Incorporation of Nanomaterials in Glass Ionomer Cements—Recent Developments and Future Perspectives: A Narrative Review. Nanomaterials 2022, 12, 3827. [Google Scholar] [CrossRef]
- ISO 9917-1; Dentistry-Water-Based Cements-Part 1: Powder/Liquid Acid-Base Cements. ISO: Geneva, Switzerland, 2007.
- ISO 9917-2; Dental-Water-Based Cements-Part 2: Light-Activated Cements. ISO: Geneva, Switzerland, 2008.
- Wetzel, R.; Eckardt, O.; Biehl, P.; Brauer, D.; Schacher, F. Effect of poly(acrylic acid) architecture on setting and mechanical properties of glass ionomer cements. Dent. Mater. 2020, 36, 377–386. [Google Scholar] [CrossRef]
- Ilie, N.; Hilton, T.J.; Heintze, S.D.; Hickel, R.; Watts, D.C. Academy of dental materials guidance—Resin composites: Part I—Mechanical properties. Dent. Mater. 2017, 33, 880–894. [Google Scholar] [CrossRef]
- Somani, R.; Jaidka, S.; Jawa, D.; Mishra, S. Comparative evaluation of smear layer removal by various chemomechanical caries removal agents: An in vitro SEM study. J. Indian Soc. Pedod. Prev. Dent. 2015, 33, 204–207. [Google Scholar] [CrossRef] [PubMed]
- Yanıkoglou, N.D.; Sakara, R.E. Test methods used in the evaluation of the structure features of the restorative materials. J. Mater. Res. Technol. 2020, 9, 9720–9734. [Google Scholar] [CrossRef]
- Pereira, L.C.; Nunes, M.C.P.; Dibb, R.G.P.; Powers, J.M.; Roulet, J.-F.; Navarro, M.F.d.L. Mechanical properties and bond strength of glass-ionomer cement. J. Adhes. Dent. 2002, 4, 73–80. [Google Scholar] [PubMed]
- Segreto, D.; Brandt, W.C.; Correr-Sobrinho, L.; Sinhoreti, M.A.; Consani, S. Influence of Irradiance on the Push-out Bond Strength of Composite Restorations Photoactivated by LED. J. Contemp. Dent. Pract. 2008, 9, 89–96. [Google Scholar] [CrossRef]
- ISO/TS 11405; Dentistry-Testing of Adhesion to Tooth Structure. ISO: Geneva, Switzerland, 2015.
- Standard 11266 I, ISO 29022; Dentistry-Adhesion-Notched Edge Shear Bond Strength Test. ISO: Geneva, Switzerland, 2014.
- Ching, H.S.; Luddin, N.; Kannan, T.P.; Ab Rahman, I.; Ghani, N.R.N.A. Modification of glass ionomer cements on their physical-mechanical and antimicrobial properties. J. Esthet. Restor. Dent. 2018, 30, 557–571. [Google Scholar] [CrossRef]
- Farrugia, C.; Camilleri, J. Antimicrobial properties of conventional restorative filling materials and advances in antimicrobial properties of composite resins and glass ionomer cements—A literature review. Dent. Mater. 2015, 31, e89–e99. [Google Scholar] [CrossRef]
- Elsaka, S.E.; Hamouda, I.M.; Swain, M.V. Titanium dioxide nanoparticles addition to a conventional glass-ionomer restorative: Influence on physical and antibacterial properties. J. Dent. 2011, 39, 589–598. [Google Scholar] [CrossRef]
- Du, X.; Huang, X.; Huang, C.; Frencken, J.; Yang, T. Inhibition of early biofilm formation by glass-ionomer incorporated with chlorhexidine in vivo: A pilot study. Aust. Dent. J. 2012, 57, 58–64. [Google Scholar] [CrossRef]
- Xie, D.; Weng, Y.; Guo, X.; Zhao, J.; Gregory, R.L.; Zheng, C. Preparation and evaluation of a novel glass-ionomer cement with antibacterial functions. Dent. Mater. 2011, 27, 487–496. [Google Scholar] [CrossRef]
- Vagner Rodrigues, S. Propolis: Alternative Medicine for the Treatment of Oral Microbial Diseases. In Alternative Medicine; Books on Demand: Norderstedt, Germany, 2012. [Google Scholar]
- Huang, X.-Y.; Guo, X.-L.; Luo, H.-L.; Fang, X.-W.; Zhu, T.-G.; Zhang, X.-L.; Chen, H.-W.; Luo, L.-P. Fast Differential Analysis of Propolis Using Surface Desorption Atmospheric Pressure Chemical Ionization Mass Spectrometry. Int. J. Anal. Chem. 2015, 2015, 176475. [Google Scholar] [CrossRef]
- Hatunoǧlu, E.; Ö Ztü Rkb, F.; Bilenler, T.; Aksakalli, S.; Ş Imşeke, N. Antibacterial and mechanical properties of propolis added to glass ionomer cement. Angle Orthod. 2014, 84, 368–373. [Google Scholar] [CrossRef] [PubMed]
- Topcuoglu, N.; Ozan, F.; Ozyurt, M.; Kulekci, G. In vitro antibacterial effects of glassionomer cement containing ethanolic extract of propolis on Streptococcus mutans. Eur. J. Dent. 2012, 6, 428–433. [Google Scholar] [CrossRef]
- Hu, J.; Du, X.; Huang, C.; Fu, D.; Ouyang, X.; Wang, Y. Antibacterial and physical properties of EGCG-containing glass ionomer cements. J. Dent. 2013, 41, 927–934. [Google Scholar] [CrossRef] [PubMed]
- Singer, L.; Bierbaum, G.; Kehl, K.; Bourauel, C. Evaluation of the Flexural Strength, Water Sorption, and Solubility of a Glass Ionomer Dental Cement Modified Using Phytomedicine. Materials 2020, 13, 5352. [Google Scholar] [CrossRef] [PubMed]
- Paulraj, J.; Nagar, P. Antimicrobial efficacy of triphala and propolis-modified glass ionomer cement: An in vitro study. Int. J. Clin. Pediatr. Dent. 2020, 13, 457–462. [Google Scholar] [CrossRef] [PubMed]
- Xool-Tamayo, J.; Chan-Zapata, I.; Arana-Argaez, V.E.; Villa-de la Torre, F.; Torres-Romero, J.C.; Araujo-Leon, J.A.; Aguilar-Ayala, F.A.; Rejón-Peraza, M.E.; Castro-Linares, N.C.; Vargas-Coronado, R.F.; et al. In vitro and in vivo anti-inflammatory properties of Mayan propolis. Eur. J. Inflamm. 2020, 18, 205873922093528. [Google Scholar] [CrossRef]
- Altunsoy, M.; Tanrıver, M.; Türkan, U.; Uslu, M.E.; Silici, S. In Vitro Evaluation of Microleakage and Microhardness of Ethanolic Extracts of Propolis in Different Proportions Added to Glass Ionomer Cement. J. Clin. Pediatr. Dent. 2016, 40, 136–140. [Google Scholar] [CrossRef] [PubMed]
- Subramaniam, P.; Babu, K.G.; Neeraja, G.; Pillai, S. Does Addition of Propolis to Glass Ionomer Cement Alter its Physicomechanical Properties? An In Vitro Study. J. Clin. Pediatr. Dent. 2017, 41, 62–65. [Google Scholar] [CrossRef]
- Andrade, A.L.; Lima, A.M.; Santos, V.R.; Da Costa e Silva, R.M.F.; Barboza, A.P.M.; Neves, B.R.A.; Vasconcellos, W.A.; Domingues, R.Z. Glass-ionomer-propolis composites for caries inhibition: Flavonoids release, physical-chemical, antibacterial and mechanical properties. Biomed. Phys. Eng. Express. 2019, 5, 027006. [Google Scholar] [CrossRef]
- Sundeep Hedge, K.; Bhat, S.; Rao, A.; Sain, S. Effect of a propolis extract on Streptococcus mutans counts: An in vivo. Int. J. Clin. Pediatr. Dent. 2013, 6, 22–25. [Google Scholar]
- Braga, R.R.; Meira, J.B.C.; Boaro, L.C.C.; Xavier, T.A. Adhesion to tooth structure: A critical review of “macro” test methods. Dent. Mater. 2010, 26, e38-49. [Google Scholar] [CrossRef] [PubMed]
- Scherrer, S.S.; Cesar, P.F.; Swain, M.V. Direct comparison of the bond strength results of the different test methods: A critical literature review. Dent. Mater. 2010, 26, e78–e93. [Google Scholar] [CrossRef] [PubMed]
- Fareed, M.A.; Stamboulis, A. Effect of Nanoclay Dispersion on the Properties of a Commercial Glass Ionomer Cement. Int. J. Biomater. 2014, 2014, 1–10. [Google Scholar] [CrossRef] [PubMed]
- Morneburg, T.; Pröschel, P. Measurement of masticatory forces and implant loads: A methodologic clinical study. Int. J. Prosthodont. 2002, 15, 20–27. [Google Scholar]
- Noori, A.J.; Kareem, F.A. Setting time, mechanical and adhesive properties of magnesium oxide nanoparticles modified glass-ionomer cement. J. Mater. Res. Technol. 2019, 9, 1809–1818. [Google Scholar] [CrossRef]
- Haghgoo, R.; Mehran, M.; Afshari, E.; Zadeh, H.F.; Ahmadvand, M. Antibacterial Effects of Different Concentrations of Althaea officinalis Root Extract versus 0.2% Chlorhexidine and Penicillin on Streptococcus mutans and Lactobacillus (In vitro). J. Int. Soc. Prev. Community Dent. 2017, 7, 180–185. [Google Scholar] [CrossRef]
- Loesche, W.J. Role of Streptococcus mutans in human dental decay. Microbiol. Rev. 1986, 50, 353–380. [Google Scholar] [CrossRef]
- Panahandeh, N.; Adinehlou, F.; Sheikh-Al-Eslamian, S.M.; Torabzadeh, H. Extract of Propolis on Resin-Modified Glass Ionomer Cement: Effect on Mechanical and Antimicrobial Properties and Dentin Bonding Strength. Int. J. Biomater. 2021, 2021, 1–7. [Google Scholar] [CrossRef]
- Geckil, H.; Ates, B.; Durmaz, G.; Erdoğan, S.; Yilmaz, I. Antioxidant, Free Radical Scavenging and Metal Chelating Characteristics of Propolis. Am. J. Biochem. Biotechnol. 2005, 1, 27–31. [Google Scholar] [CrossRef]
- Bala, O.; Arisu, H.D.; Yikilgan, I.; Arslan, S.; Gullu, A. Evaluation of surface roughness and hardness of different glass ionomer cements. Eur. J. Dent. 2012, 6, 79–86. [Google Scholar]
- Ekambaram, M.; Yiu, C. Bonding to hypomineralized enamel—A systematic review. Int. J. Adhes. Adhes. 2016, 69, 27–32. [Google Scholar] [CrossRef]
- Tedesco, T.K.; Calvo, A.F.B.; Domingues, G.G.; Mendes, F.M.; Raggio, D.P. Bond Strength of High-Viscosity Glass Ionomer Cements is Affected by Tubular Density and Location in Dentin? Microsc. Microanal. 2015, 21, 849–854. [Google Scholar] [CrossRef] [PubMed]
- Zheng, B.; Cao, S.; Al-Somairi, M.A.A.; He, J.; Liu, Y. Effect of enamel-surface modifications on shear bond strength using different adhesive materials. BMC Oral Health 2022, 22, 224. [Google Scholar] [CrossRef] [PubMed]
- Kaptan, A.; Oznurhan, F.; Candan, M. In Vitro Comparison of Surface Roughness, Flexural, and Microtensile Strength of Various Glass-Ionomer-Based Materials and a New Alkasite Restorative Material. Polymers 2023, 15, 650. [Google Scholar] [CrossRef] [PubMed]
- Francois, P.; Vennat, E.; Le Goff, S.; Ruscassier, N.; Attal, J.-P.; Dursun, E. Shear bond strength and interface analysis between a resin composite and a recent high-viscous glass ionomer cement bonded with various adhesive systems. Clin. Oral Investig. 2018, 23, 2599–2608. [Google Scholar] [CrossRef] [PubMed]

| Sample | Preparation |
|---|---|
| PAC | Unmodified material |
| 25MPAC | PAC + 25 µL of propolis |
| 50MPAC | PAC + 50 µL of propolis |
| MPAC-NA | PAC + 10 µL without acid tissue conditioning |
| MPAC-A | PAC + 10 µL with acid tissue conditioning |
| PAC-NA | PAC without acid tissue conditioning |
| PAC-A | PAC with acid tissue conditioning |
| FASP | Fluoroaluminosilicate powder |
| Sample | Compressive Properties | Bending Properties | ||||
|---|---|---|---|---|---|---|
| EC (MPa) | σC (MPa) * | εC (%) | EF (GPa) | σF (MPa) * | εF (%) | |
| PAC | 89.44 ± 8.88 | 211.21 ± 8.83 a | 2.45 ± 0.33 | 19.72 ± 6.40 | 11.10 ± 1.71 a | 0.10 ± 0.02 |
| 25MPAC | 34.7 ± 7.13 | 94.40 ± 9.62 b | 2.43 ± 0.26 | 7.12 ± 2.51 | 7.78 ± 1.41 b | 0.29 ± 0.092 |
| 50MPAC | 20.4 ± 3.5 | 59.36 ± 2.45 b | 3.23 ± 0.15 | 3.53 ± 1.76 | 6.25 ± 1.85 b | 0.42 ± 0.16 |
| Sample | Shear Force (N) * | Shear Strength (MPa) * | Pull-Out Force (N) * |
|---|---|---|---|
| PAC-A | 19.3 ± 6.0 a | 1.70 ± 0.53 a | 206.6 ± 27.1 a |
| PAC-NA | 7.02 ± 3.0 b | 0.62 ± 0.27 b | 151.4 ± 92.4 a |
| 25MPAC | 16.6 ± 2.4 a | 1.47 ±0.211 a | - |
| MPAC-A | 19.4 ± 8.4 a | 1.71 ± 0.74 a | 57.1 ± 12.5 b |
Disclaimer/Publisher’s Note: The statements, opinions and data contained in all publications are solely those of the individual author(s) and contributor(s) and not of MDPI and/or the editor(s). MDPI and/or the editor(s) disclaim responsibility for any injury to people or property resulting from any ideas, methods, instructions or products referred to in the content. |
© 2023 by the authors. Licensee MDPI, Basel, Switzerland. This article is an open access article distributed under the terms and conditions of the Creative Commons Attribution (CC BY) license (https://creativecommons.org/licenses/by/4.0/).
Share and Cite
Aguilar-Perez, D.A.; Urbina-Mendez, C.M.; Maldonado-Gallegos, B.; Castillo-Cruz, O.d.J.; Aguilar-Ayala, F.J.; Chuc-Gamboa, M.G.; Vargas-Coronado, R.F.; Cauich-Rodriguez, J.V. Mechanical Properties of Poly(Alkenoate) Cement Modified with Propolis as an Antiseptic. Polymers 2023, 15, 1676. https://doi.org/10.3390/polym15071676
Aguilar-Perez DA, Urbina-Mendez CM, Maldonado-Gallegos B, Castillo-Cruz OdJ, Aguilar-Ayala FJ, Chuc-Gamboa MG, Vargas-Coronado RF, Cauich-Rodriguez JV. Mechanical Properties of Poly(Alkenoate) Cement Modified with Propolis as an Antiseptic. Polymers. 2023; 15(7):1676. https://doi.org/10.3390/polym15071676
Chicago/Turabian StyleAguilar-Perez, David Alejandro, Cindy Maria Urbina-Mendez, Beatriz Maldonado-Gallegos, Omar de Jesus Castillo-Cruz, Fernando Javier Aguilar-Ayala, Martha Gabriela Chuc-Gamboa, Rossana Faride Vargas-Coronado, and Juan Valerio Cauich-Rodriguez. 2023. "Mechanical Properties of Poly(Alkenoate) Cement Modified with Propolis as an Antiseptic" Polymers 15, no. 7: 1676. https://doi.org/10.3390/polym15071676
APA StyleAguilar-Perez, D. A., Urbina-Mendez, C. M., Maldonado-Gallegos, B., Castillo-Cruz, O. d. J., Aguilar-Ayala, F. J., Chuc-Gamboa, M. G., Vargas-Coronado, R. F., & Cauich-Rodriguez, J. V. (2023). Mechanical Properties of Poly(Alkenoate) Cement Modified with Propolis as an Antiseptic. Polymers, 15(7), 1676. https://doi.org/10.3390/polym15071676









